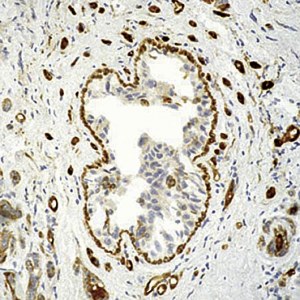
Antibody validation in IHC on frozen tissue slides

Antibody validation

Antibody validation in Immunoprecipitation
We perform your immunoprecipitations experiments from your antibodies or proteins or from the one developed by our custom service. => Quotation request
 |

Antibody validation in ELISA
We test your antibodies in ELISA. => Quotation request
 |

Antibody validation in WB
We perform your western blotting experiments on any type of biological material. => Quotation request
 |

Antibody validation in IHC on TMA
This analysis is realized in normal and cancerous formalin-fixed and paraffin-embedded (FFPE) Tissue Micro-Arrays (TMA). => Quotation request
 |
Antibody validation in IHC on frozen tissue slides
This analysis is realized in single sections of normal and cancerous formalin-fixed frozen tissues. => Quotation request
 |

